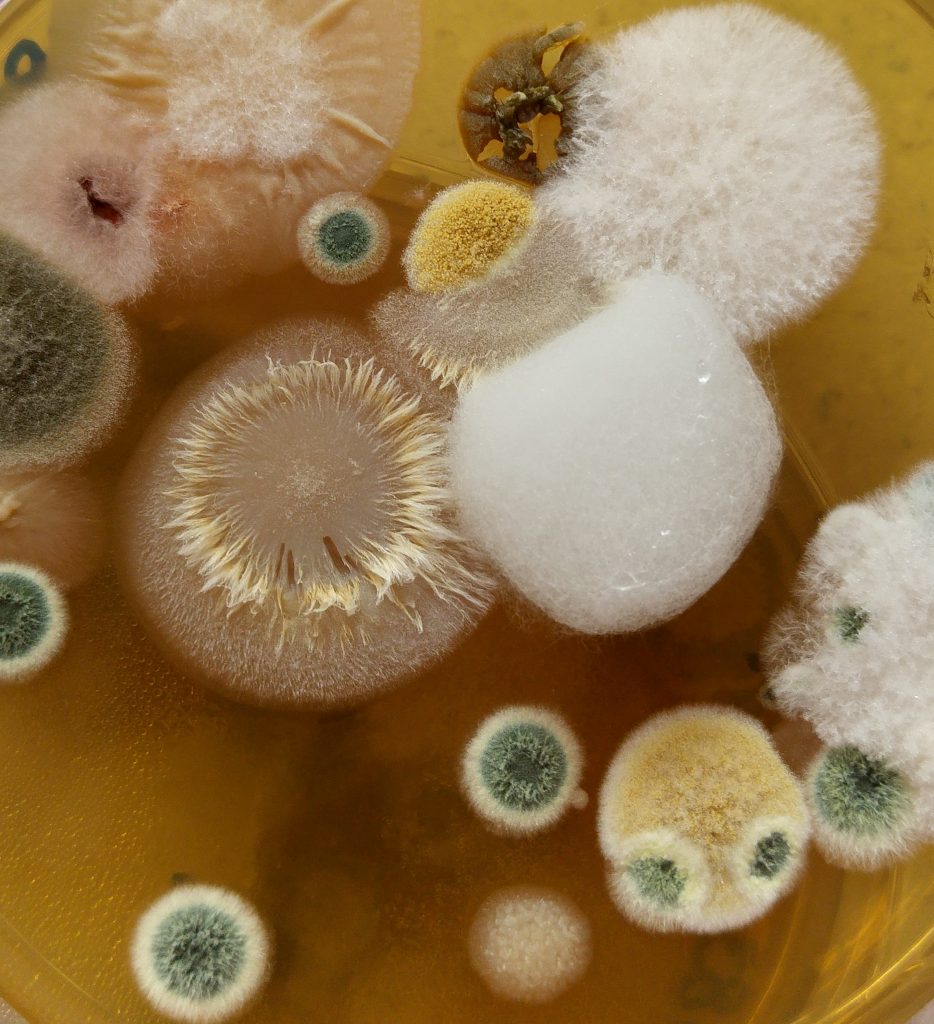

Плесневые грибы вызывают заболевания
Длинная река канада
Погода квашино воробьевский
Составить слово из слова мангал
Caterpillar английский
Uperwood magenta
Герой карданов
Принц тритон актер
Рецепт салата на зиму шакароб в банках
Пробздеться
Сообщение про майю плисецкую
Научный доклад о медведях 5 класс кратко
Жена эдриан
Первоклашка первоклассник у тебя сегодня праздник слова
Плесневые грибы вызывают заболевания 116 фото